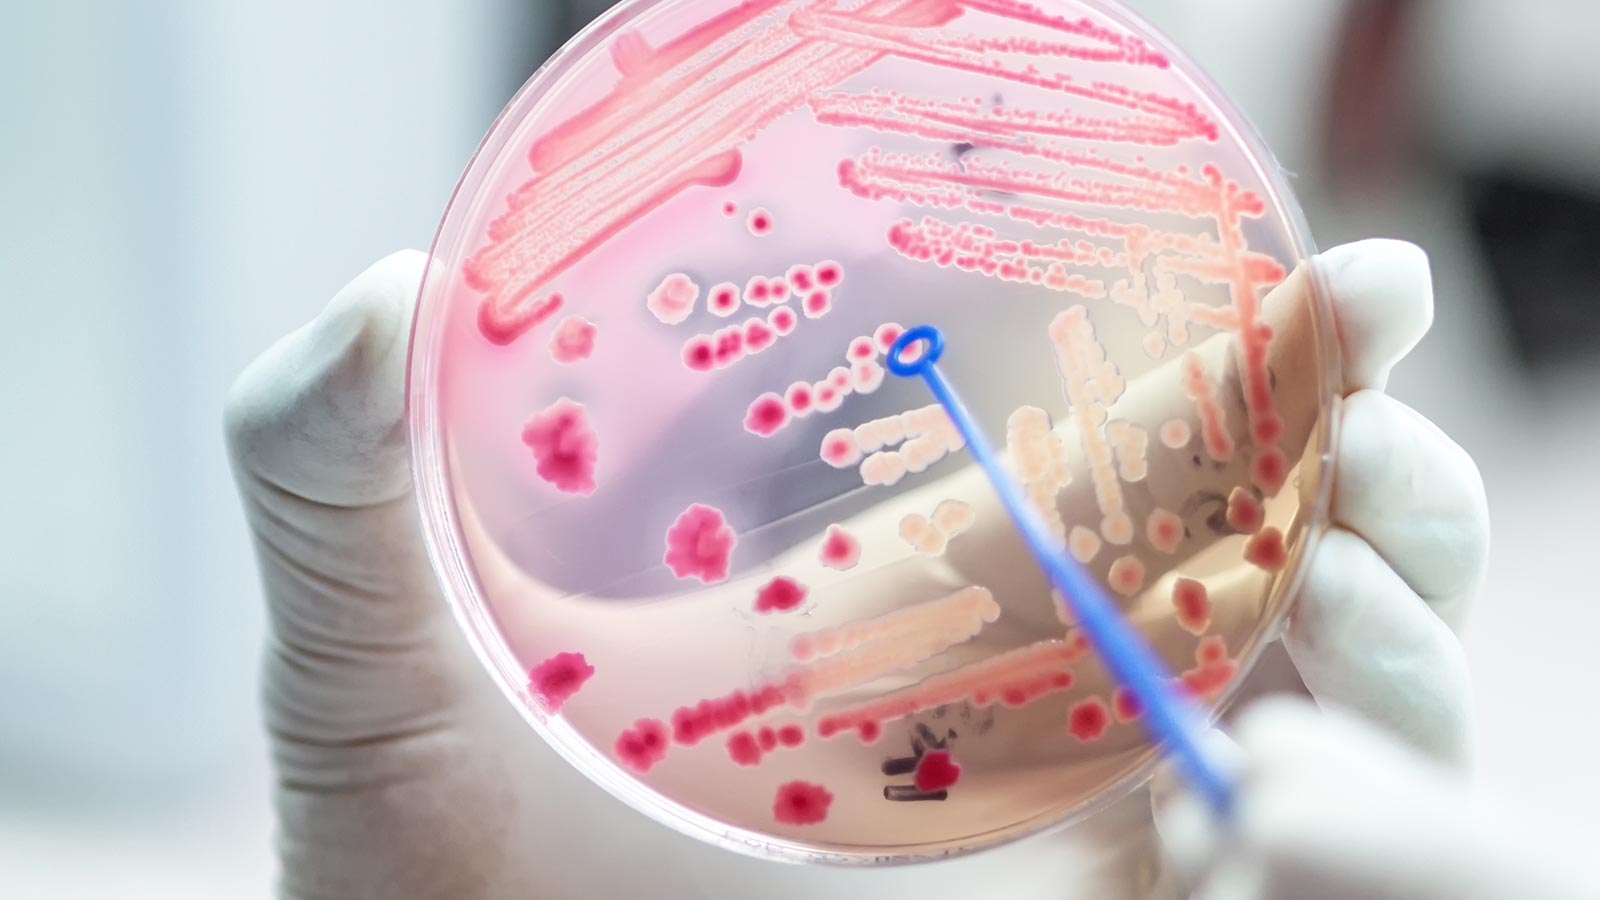

Los consumidores, contra las bacterias resistentes
El mal uso de los antibióticos en animales destinados a la producción de alimentos es uno de los responsables de las resistencias bacterianas. El BEUC inició hace unas semanas su campaña de sensibilización sobre las resistencias antibióticas, el #SuperBugTour. La superbacteria ha llegado a nuestro país: los consumidores españoles nos movilizamos para combatirla.
Los antibióticos son indispensables para nuestra salud, son los únicos fármacos que pueden acabar con determinadas enfermedades. Sin embargo, el mal uso y el abuso de los antibióticos ha estimulado la resistencia de las bacterias, hasta el punto que ha creado uno de los principales problemas de salud pública en Europa.
El recurso sistemático a los antibióticos en animales destinados a la producción alimentaria es uno de los ejemplos más claros de mal uso de antibióticos. Y precisamente, según la Agencia Europea de Medicamentos (EMA), España es el país de la Unión Europea donde más antibióticos veterinarios se venden, la mayoría de ellos destinados a su uso en ganadería: este es un grave riesgo para la salud humana.
BEUC, contra las superbacterias
BEUC, la Organización Europea de Consumidores, lleva mucho tiempo trabajando para sensibilizar a los consumidores europeos sobre el grave riesgo que suponen las resistencias a los antibióticos, sobre el problema que es que las resistencias se hagan fuertes y los fármacos ya no lleguen a ser capaces de eliminarlas. Fruto de ese compromiso de los consumidores europeos con este tema es la creación de la campaña #SuperBugTour, que hoy ha llegado a nuestro país.
Campaña de BEUC contra resistencia antibiótica
Movilízate con OCU y los consumidores europeos
En OCU estamos convencidos de lo grave del problema y por ello nos sumamos a la campaña europea puesta en marcha por el BEUC, para exigir a los Ministerios de Sanidad y Agricultura de toda la Unión Europea un uso más responsable de los antibióticos en los animales destinados a la producción de alimentos: es la única manera de conseguir frenar el crecimiento desmedido de las bacterias resistentes.

Queremos atajar de raíz el problema. OCU, coincidiendo con la llegada a España de #SuperBugTour, inicia en su página Movilízate una campaña nacional destinada a acabar con el crecimiento de las resistencias baceterias. Queremos conseguir que:
- Se cambie la normativa, de forma que solo se permita el uso de antibióticos en animales enfermos.España tiene el dudoso honor de ser el líder en uso de antibióticos en animales.
- Se reserven para uso exclusivamente humano los antibióticos en los que ya se haya encontrado una elevada tasa de resistencias.
- Se refuercen los controles para supervisar el cumplimiento de la normativa.
- Se mejoren las prácticas de higiene y cuidado de los animales en las granjas, con lo que se reduciría la necesidad de recurrir a los antibióticos.
¿Nos ayudas a lograrlo?
Apoya con tu firma nuestra campaña
#SuperbugTour una campaña de sensibilización en toda Europa